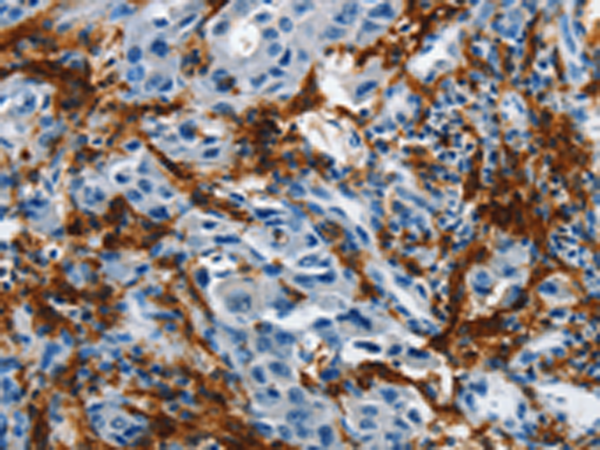
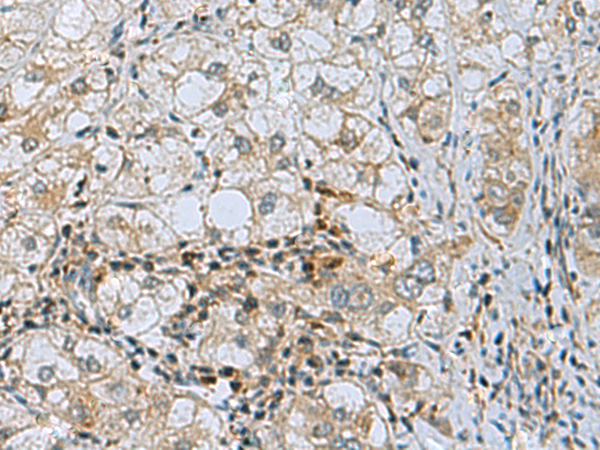

-
分类: 科研抗体货号: P00127别名: IL-20R1; ZCYTOR7应用: IHC反应种属: Human, Mouse
-
分类: 科研抗体货号: P00080别名: MMP-7, MPSL1, PUMP-1应用: WB反应种属: Human
-
分类: 科研抗体货号: P00126别名: IL1RB, CD121b, CDw121b, IL-1R-2, IL-1RT2, IL-1RT-2应用: IHC反应种属: Human
-
分类: 科研抗体货号: P00068别名: MCH3; CMH-1; LICE2; CASP-7; ICE-LAP3应用: WB,IHC反应种属: Human, Mouse
-
分类: 科研抗体货号: P00124别名: FVH; IL18BPa应用: WB反应种属: Human, Mouse, Rat
-
分类: 科研抗体货号: P00066别名: ICH1, NEDD2, CASP-2, NEDD-2应用: WB反应种属: Human, Mouse, Rat
-
分类: 科研抗体货号: P00120别名: NR4; CT19; CD213A1; IL-13Ra应用: WB,IHC反应种属: Human, Mouse
-
分类: 科研抗体货号: P00059别名: PP4, ANX5, ENX2, RPRGL应用: WB,IHC反应种属: Human, Mouse, Rat
-
分类: 科研抗体货号: P00113别名: Bfk; C1orf178应用: WB,IHC反应种属: Human, Mouse
-
分类: 科研抗体货号: P00047别名: ALK4; SKR2; ACTRIB; ACVRLK4应用: WB,IHC反应种属: Human, Mouse, Rat

鄂公网安备42018502007531号
鄂公网安备42018502007531号

